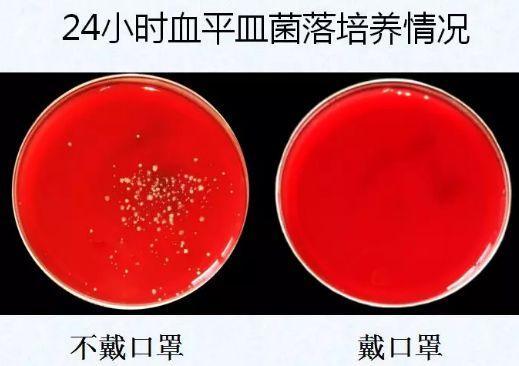
打喷嚏时用手捂居然是错的?这样做才能有礼貌还不传播疾病

打喷嚏时飞沫能荟萃两米!
万万不要蔑视一个喷嚏的威力,喷嚏不仅随身带多量的微生物,同时它还具有强大的喷射力。
据钻研质料表述,当咱们打喷嚏时,通过鼻腔与口腔同时排气,唾液、鼻腔分泌物会形成1000-40000粒飞沫随气氛高速喷出,能够把细菌或病毒带到2米支配的隔断。
所以,不要以为你不有与病人措辞或交兵就不会被污染,这也是为甚么在流感高发季,提倡人人不要去打胎麋集的中央和屡屡坚持透风的缘故原由。
那不少人就是由于怕把病菌传染给外人,所以打喷嚏时才捂着嘴,怎样就舛误了呢?
打喷嚏捂嘴究竟对差迟?
固然打喷嚏时用手捂钳口鼻,的确盖住了飞沫向氛围中传达,然而微生物会附着在手上,假定你不及时洗手,你再摸身体其他部位时,微生物会很容易进入眼睛和鼻子,造成感染。
假定你在群众场所,笼统会再去构兵楼梯栏杆、地铁拉环、公交车扶手、门把手等群众物品,就会将病毒传播到这些物品上,阴森的是,病毒能够在空气中存活几小时,如许就极易将病毒净化给外人。
值得属意的是,即使是健康人打喷嚏,制作生的飞沫中也梗概随身带细菌或病毒!
打喷嚏姿式很紧要!
打喷嚏是人体的犯警戍守,然则想要打得有端方,还不传播疾病,打喷嚏的姿势很需求!
01、用手帕或纸巾遮挡
在平常保管中,打喷嚏或咳嗽时,可以用纸巾遮掩口鼻。
02、用手肘衣袖遮挡
要是历久情急,来不及操办,可以用肘部衣袖遮掩。因为肘部兵戈其他中央的机缘少,不简单造成细菌和病毒的散布。
03、万万不克不及憋着不打
有了一部份人在公众场所出于正直或是防止难堪,憋着喷嚏不打,这么做的确很危险!
因为要是这个时辰你硬要憋回去,打喷嚏发生发火的压力得不到囚系,会经由过程咽鼓管感召于耳道鼓膜,严重时会造成鼓膜穿孔。
其余,憋归去的细菌、病毒等会随着气流由咽鼓管进入压力低的中耳鼓室,从而诱焦虑性中耳炎。
04、最好坐着或半蹲
得多人在打喷嚏时习尚性弯腰低头,确实这种做法也是错误的。打喷嚏时弯腰这个瞬时步履,大要因暴烈的腰肌扭动、不答腔压缩而引起腰肌毁伤(闪了腰)。
倡议打喷嚏时要保持良好姿式,如鼻子发痒了就做好准备,坐着比站着好。站着打喷嚏的时候,手最佳扶着一样器械,坐着或半蹲时,可以挺胸直腰,双髋、膝关节稍微愚昧,膨胀腰部肌肉,防御身体受伤。
05、罹病时请带口罩
假如已经泛起染病咳嗽打喷嚏的症状,理应只管即便与他人保持2米以上的间隔,假如在人员麋集的场所(如在早顶峰的地铁、公交车上),可以颠末佩戴口罩防备撒播给他人。
小暗示
教会家人打喷嚏的切确姿式,可以防止家庭内部穿插感染。此外延幼儿园里,老师最佳也教给幼儿粗略打喷嚏的方法,由于要是孩子用手来遮缄口鼻,病毒会到宝宝手上,随着孩子的手触摸上任何一小我或玩具上,病毒就有或是传给所兵戈的人,接下来循环往复,感冒病毒就敏捷传布开了。




